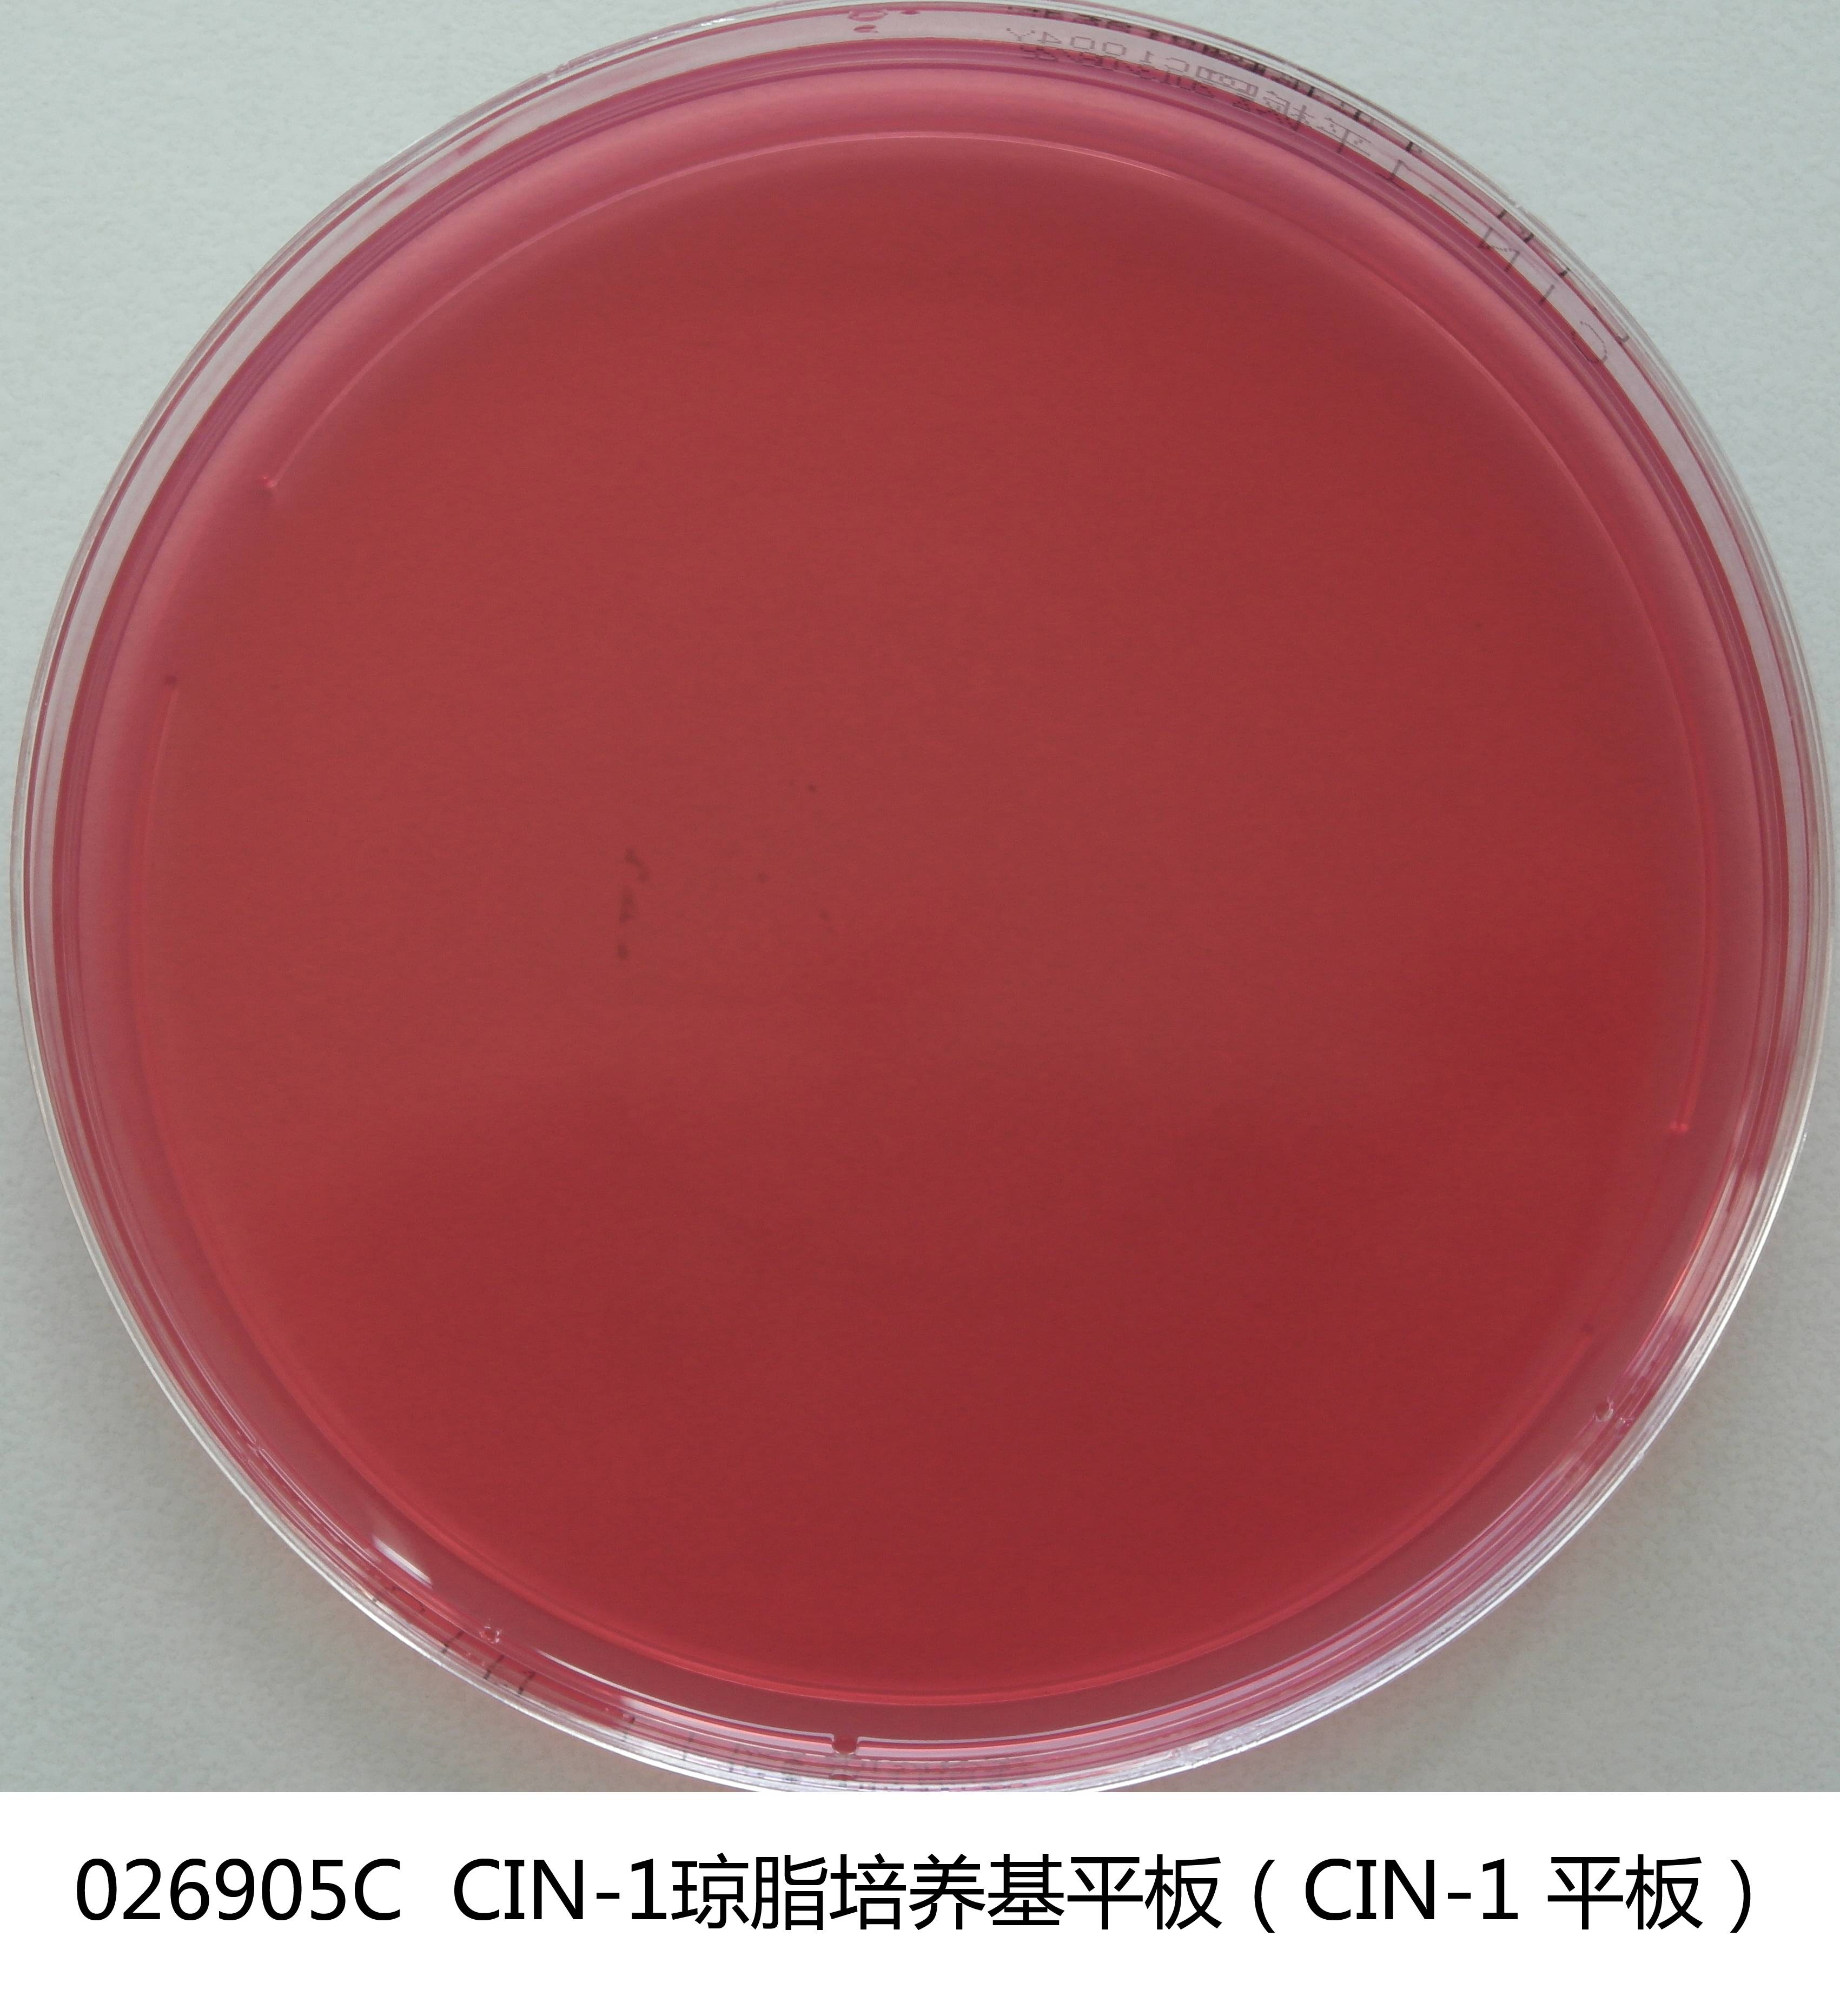

商品详细
说明书
微生物图册
行业应用
相关论文
产品名称:CIN-1琼脂平板
英文名称:CIN-1 Medium Plate
产品编号与包装规格:
| 产品编号 | 产品类型 | 包装规格 |
|---|---|---|
| 026905C | 即用型成品平板 | 90mm×20个/盒 |
产品用途:用于小肠结肠炎耶尔森氏菌的选择性分离和培养。
检验原理:胰胨和酵母浸膏提供氮源和微量元素;甘露醇为可发酵糖;去氧胆酸钠和结晶紫抑制革兰氏阳性菌;中性红是pH指示剂;琼脂是培养基的凝固剂。
CIN-1琼脂平板培养基配方成分:
| 配方(每升) | 含量 |
|---|---|
| 胰胨 | 20.0g |
| 酵母浸膏 | 2.0g |
| 甘露醇 | 20.0g |
| 氯化钠 | 1.0g |
| 去氧胆酸钠 | 2.0g |
| 硫酸镁(MgSO4.7H2O) | 0.01g |
| 中性红 | 0.03g |
| 结晶紫 | 0.001g |
| 琼脂 | 12.0g |
| 0.04%二苯醚乙醇 | 10mL |
| 头孢磺啶 | 15mg |
| 新生霉素 | 2.5mg |
| 氯化锶 | 1g |
| 蒸馏水 | 1000mL |
| 最终pH 7.5±0.2 | |
使用方法:拆开包装即可使用。
CIN-1琼脂平板培养基质量控制(下列质控菌株接种后于26±1℃培养48h,观察结果如下表:):
| 指标 | 质控菌株及编号 | 标准值 | 特征性反应 |
|---|---|---|---|
| 生长率 | 小肠结肠炎耶尔森氏菌CMCC(B)52204 | PR≥0.5 | 菌落圆形、红色,边缘透明,中央色深,呈牛眼状 |
| 选择性 | 大肠埃希氏菌ATCC25922 | G≤1 | —— |
| 粪肠球菌ATCC29212 | —— |
储存条件与保质期:2-8℃避光保存,有效期见产品标签。
注意事项:一次性平板培养基置于冰箱冷藏保存需与存放容器冷凝管保持一定距离以避免冻损坏。产品多次在低温与常温之间变更会引起琼脂的泌水,属于正常现象。使用前应平衡至室温且尽量在无菌干燥箱中预干燥。
参考文献:GB 4789.8-2016 中华人民共和国国家标准 食品卫生微生物学检验 小肠结肠炎耶尔森氏菌检验